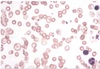

Pathologic RBC forms Flashcards

Acanthocyte (spur cell)
Liver disease, abetalipoproteinemia (cholesterol dysregulation)
Acantho = spiny

Basophilic stippling
[Baste the ox TAiL]
Thalassemia, Anemia of chronic disease, Lead poisoning

Bite Cell
G6PD Deficiency

Elliptocyte
Hereditary elliptocytosis

Macro-ovalocyte
Megaloblastic anemia (also hypersegmented PMNs), marrow failure

Ringed sideroblasts
Sideroblastic anemia
Excess iron in mitochondria = pathologic

Schistocyte, helmet cell
DIC, TTP/HUS, traumatic hemolysis (metal heart valve prosthesis)

Sickle cell
Sickle cell anemia

Spherocyte
Hereditary spherocytosis, autoimmune hemolysis

Teardrop cell
Bone marrow infiltration (e.g. myelofibrosis)

Target cell
[HALT says the hunter]
HbC disease, Asplenia, Liver disease, Thalassemia

Heinz bodies
G6PD; Heinz body-like inclusions in alpha-thalassemia
Oxidation of iron from ferrous to ferric leads to denatred hemoglobin precipitation and damage to RBC membrane -> formation of bite cells

Howell-Jolly bodies
Functional hyposplenia or asplenia; after mothball ingestion (naphthalene)
Basophilic nuclear remnants in RBCs
Normally removed from RBCs by splenic macrophages

Iron deficiency. Note microcytosis and hypochromia
Beta-thalassemia major
Note anisocytosis, poikilocytosis, microcytosis, hypochromia, target cells and schistocytes

Sickle cell disease

Reed-Sternberg Cells
2 halves as mirror images (“owl’s eyes”)
See in Hodgkin’s disease

Burkitt’s lymphoma
“Starry sky” appearance: sheets of lymphocytes with interspersed macrophages

Multiple myeloma
Monoclonal plasma cell (“fried egg” appearancce)
Clock face chromatin (black arrow) and whitish intracytoplasmic inclusions containing immunoglobulin

Acute Lymphoblastic Leukemia/Lymphoma

Small lymphocytic lymphoma/Chronic lymphocytic leukemia
Smudge cells in peripheral blood smear

Hairy cell leukemia
Cells have filamentous, hair-like projections

Acute myelogenous leukemia

Chronic myelogenous leukemia (CML)
Increased in neutrophils, metamyelocytes, basophils
